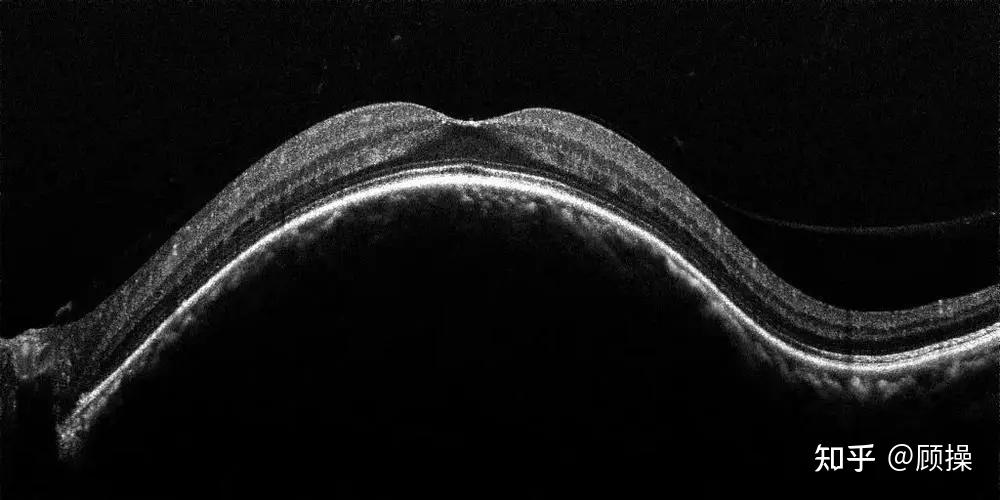
今天讲讲"脉络膜血管瘤"

脉络膜血管瘤

这是脉络膜血管瘤吗?
图片尺寸1280x1024
皮肤血管瘤的类型和治疗概况
图片尺寸2250x4000
考虑脉络膜黑色素瘤吗
图片尺寸4032x3024
聊聊脉络膜血管瘤 - 知乎
图片尺寸1275x819
视网膜血管瘤
图片尺寸300x224
走进"婴幼儿血管瘤"的世界——高清大图下的细节辨识和诊疗精要_皮肤
图片尺寸2415x3095
走进"婴幼儿血管瘤"的世界——高清大图下的细节辨识和诊疗精要_皮肤
图片尺寸1070x1311
今天讲讲"脉络膜血管瘤"
图片尺寸547x451
saybye"天使吻痕"---六医核医学科重启婴幼儿血管瘤锶-90敷贴治疗
图片尺寸735x502
脉络膜血管瘤眼底彩照
图片尺寸500x388
资源脉络膜骨瘤
图片尺寸768x576
今天讲讲"脉络膜血管瘤"
图片尺寸1000x500
什么是血管瘤?_5.jpg
图片尺寸2560x1440
什么是先天性血管瘤如何治疗
图片尺寸4608x3456
走进"婴幼儿血管瘤"的世界——高清大图下的细节辨识和诊疗精要_皮肤
图片尺寸1648x1136
中级病例 | 脉络膜黑色素瘤影像表现
图片尺寸370x289
脉络膜乳头状瘤及室管膜瘤的诊断
图片尺寸2000x2637
血管瘤的推荐治疗方法 - 好大夫在线
图片尺寸1104x1534
脉络膜血管瘤激光治疗后
图片尺寸1650x1340
血管瘤保险公司理赔吗 血管瘤微创保险公司理赔吗
图片尺寸1650x1340